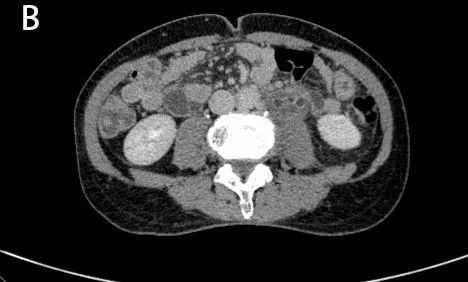

【德利专栏】为哈尔滨医科大学附属第六医院的赵德利教授授权发布,不定期更新赵教授在工作中的经验总结。让我们在收获知识的同时,为赵教授打call。
作者:袁宇,乔冠中,张金玲,赵德利*
哈尔滨医科大学附属第二医院
*哈尔滨医科大学附属第六医院
自发性输尿管破裂是一种少见疾病,分为创伤性和非创伤性,非创伤性通常是由于结石导致尿路梗阻引起的,其次是由盆腔肿块、妊娠、腹膜后纤维化及膀胱癌所致。而由于各种原因引起输尿管自发性撕裂形成夹层的情况更是罕见,因而认识不足,延误诊断。
发病机制
输尿管夹层的发病机制尚不清楚,其发病机制可能与主动脉夹层相似。输尿管为细长的肌性管道,其管壁由黏膜层、肌层、结缔组织三层构成,其中中上段管壁肌层有内纵、外环两层平滑肌,较薄弱,具备形成夹层的潜在因素。而下段管壁肌层有内、中、外三层,故夹层多发生于中上段。
输尿管夹层形成的直接原因是输尿管粘膜损伤和各种病因导致的尿路梗阻引起管腔内压力增高,当压力超过20至75mmHg的临界水平时,肾脏可能通过两种机制缓解增高的压力。一种是肾血流明显减低, 尿液生成减少, 肾盂积水速度减慢, 伴有严重的肾功能损害。另一种是尿液出现各种逆流和渗漏, 其中以肾盂肾窦逆流最常见, 此种逆流容易发生在肾盏穹隆部, 由此渗漏至肾外而形成尿瘤,其次是上段输尿管,发生在中上段输尿管的渗漏,我们将其称之为“输尿管夹层”,二者也可同时存在。
当输尿管粘膜损伤后,加之尿路梗阻时管腔压力较大,尿液外渗将管壁肌层分为内、外两层,形成真、假两个输尿管腔,其CT征象与主动脉夹层及其相似。
症状体征
输尿管自发性破裂通常无特征性临床体征。在体格检查时,患者可能有腹部压痛和疼痛,同侧有肋脊角压痛。在某些情况下,由于非特异性症状,诊断可能会很困难。鉴别诊断包括尿石症、阑尾炎、胆囊炎、憩室炎和其他可能的腹痛原因。输尿管破裂常表现为靠近腹膜的胃肠道症状,如恶心、呕吐等,可引起化学腹膜刺激,类似憩室炎或阑尾炎。
CT征象
CT平扫表现为肾脏及输尿管扩张积水,CT增强扫描呈典型的“双环及双腔样”改变,早期真腔(外腔)密度增高,随着时间的延迟,造影剂通过破口渗入假腔,排泄期假腔(内腔)密度增高。

图1A

图1B
图1A、B:CT平扫示左肾及左侧输尿管扩张积水。

图2A
图2B
图2A、B:CT增强扫描呈双环及双腔改变 ,早期可见外腔密度增高。

图3A

图3B
图3A、B:CT增强排泄期则显示内腔密度增高。

图4A

图4B

图4C
图4A-C:左侧肾盂及输尿管上段呈“双环及双腔样”改变,考虑夹层形成;三维重建可清楚的观察到撕裂肾盂及输尿管的真假腔并显示撕裂范围。
虽然输尿管夹层总体患病率较低,但一旦继续发展导致输尿管破裂,可引起输尿管瘤、腹膜后脓肿形成、脓毒症等严重并发症。因此对于出现腰部压痛、恶心呕吐的患者,尤其是同时存在尿路梗阻的患者,在进行鉴别诊断时,应将输尿管夹层考虑在内。一旦明确诊断因根据病因进行个体化治疗。
参考文献
[1]黎江芽,易建根,彭细果.输尿管夹层的影像学诊断(附3例报告)[J].临床放射学杂志,2001(01):76-77.[2] Gershman B, Kulkarni N, Sahani D V, et al. Causes of renal forniceal rupture[J]. BJU Int,2011,108(11):1909-1911, 1912.[3] Pampana E, Altobelli S, Morini M, et al. Spontaneous ureteral rupture diagnosis and treatment[J]. Case Rep Radiol,2013,2013:851859.[4] Tien R, Shirkhoda A, David R. Circumferential perirenal urinoma mimicking nephromegaly on urography[J]. Urol Radiol,1989,11(2):92-96.[5] Friedenberg R M, Moorehouse H, Gade M. Urinomas secondary to pyelosinus backflow[J]. Urol Radiol,1983,5(1):23-29.
【版权声明】本平台属公益学习平台,转载系出于传递更多学习信息之目的,且已标明作者和出处,如不希望被传播的老师可与我们联系删除
版权声明:CosMeDna所有作品(图文、音视频)均由用户自行上传分享,仅供网友学习交流。若您的权利被侵害,请联系删除!
本文链接://www.cosmedna.com/article/565323729.html







